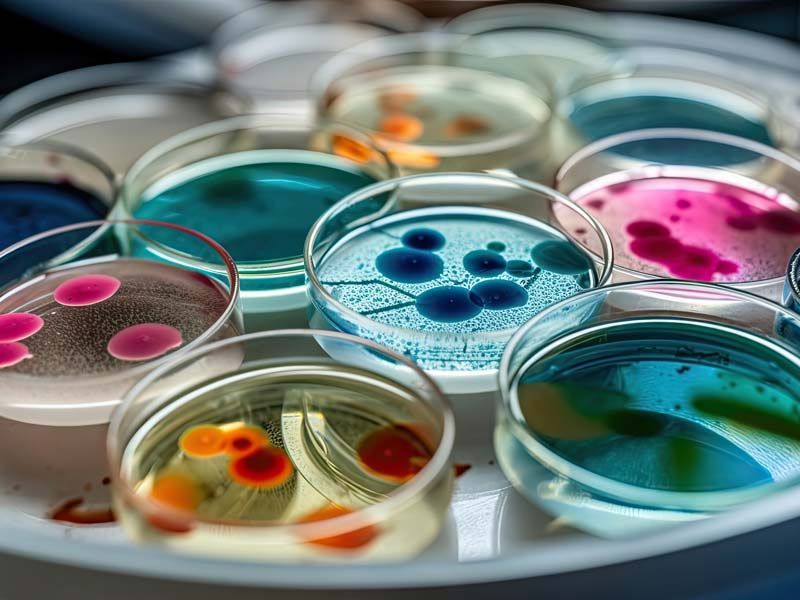
microbiologie hygiène
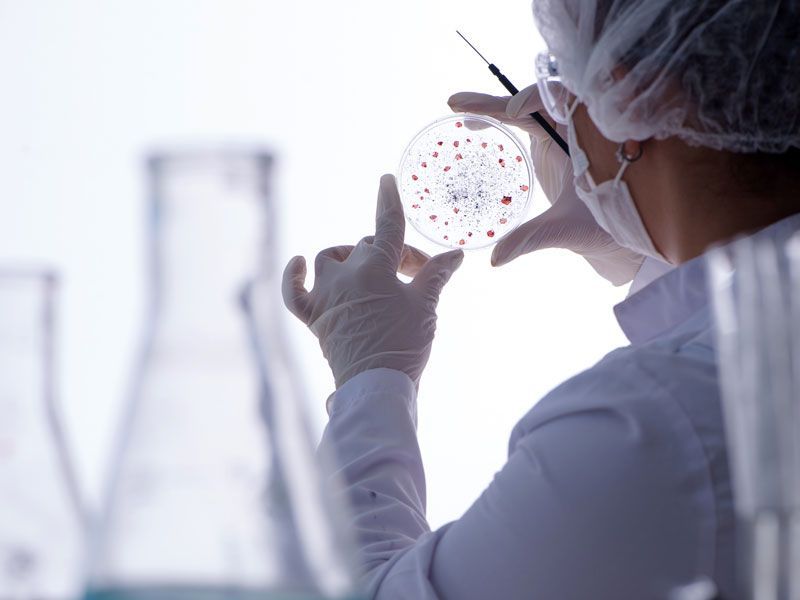
contrôles sanitaire

PRÉDEL :
filtration, œnologie et microbiologie
FILTRATION : eau et applications vinicoles
Une gamme complète de cartouches, carters, capsules de filtration et appareil de mesure d’indice de colmatage
Nous vous proposons, pour les vins rouges, blancs et rosés, des plaques filtrantes en profondeur EUROPOR®, BECOPAD®. Couvrant une gamme complète de degrés de filtration, ces plaques présentent de nombreux avantages.
Une rétention fiable des composants indésirables grâce à une structure de pores idéale, une excellente efficacité de clarification. Vous recherchez des plaques et modules lenticulaires, des cartouches et des carters de filtration ? Nous sommes présents pour vous conseiller.
OENOLOGIE :
Une gamme complète de produits œnologiques (mannoprotéines, levures, enzymes, produit de levures…)
Produits spécifiques œnologiques :
levures, enzymes, activateurs de fermentation, protection des moûts, bactéries, collage, stabilisation, produits de levure, levures liquides… Notre société PRÉDEL offre une gamme de produits œnologiques issus des dernières recherches en matière de biotechnologie afin de répondre aux besoins spécifiques de chaque vinification.
Grâce à des partenariats forts,
Grâce à des partenariats forts, tant dans le domaine de la recherche que dans le domaine industriel, la gamme que nous vous proposons aujourd’hui est exhaustive et adaptée. Notre expérience en la matière nous permet de certifier la qualité des produits de la gamme PRÉDEL ŒNOLOGIE.
Tous les produits proposés sont conformes au
Codex Œnologique International
MICROBIOLOGIE ET HYGIENE :
Filtration, laboratoire et analyses

Grâce à notre gamme Microbiologie et hygiène, nous mettons à votre disposition des outils et services pour la détection des contaminations. Parmi les équipements de laboratoire que nous proposons à la vente sont, entre autres, des rampes de filtration, des entonnoirs individuels de contrôle.
La performance et l’innovation constituent les deux axes majeurs de notre politique de recherche et développement. Ainsi, nous accordons une part importante à la microbiologie et à l’hygiène.
Nous proposons également des contrôles sanitaires par bioluminescence, des contrôles microbiologiques et des tests de valeur désinfectante pour les solutions de nettoyage. Enfin, nous proposons des tests de filtrabilité et d’indice de colmatage.







